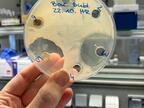

Navigation
Detail
L: Lakritz, Lakritze, Lakritzschnecke

Urheber:
Christine Pannen, CC0
Bildnummer:
P14165
Auflösung:
298x320
Format:
PNG
Quelle:
https://www.schulportal-thueringen.de/pixiothek/detail?tspi=P14165
Kurzbeschreibung:
Das Bild gehört zur Serie "Grundschulwortbilder". Es zeigt eine Lakritzschnecke als Symbolbild für den Buchstaben L. Das Bild ist unter CC0 lizenziert und kann somit frei verwendet werden. Es ist neben weiteren Bildern auch hier zu finden: https://moodlelab.moodleschule.de/
Verwandte Bilder (Auswahl)
Bakterienkultur mit Antibiotika, Ingw...
(1200x1600)

Melisse, Zitronenmelisse
(2160x1440)

Zitrone
(850x790)

Zitrone
(2048x2048)

Z: Zitrone
(320x274)
Verwandte Medien (Auswahl)
Es wurden aktuell keine verwandten Medien gefunden.





